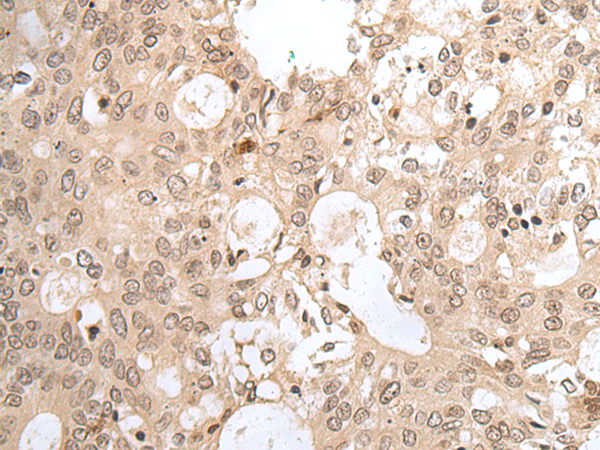
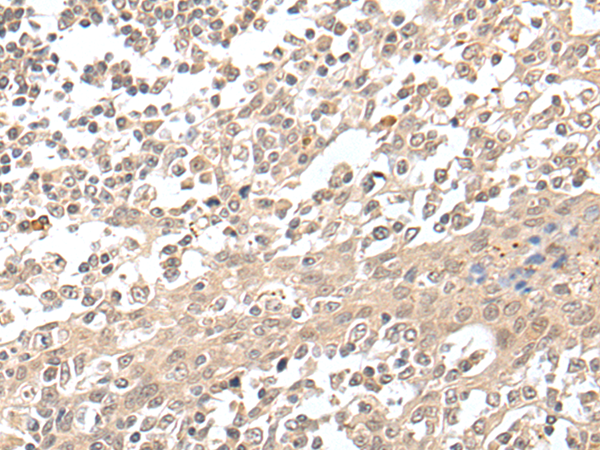

中文名稱: 兔抗HCN3多克隆抗體
宿 主: Rabbit
抗 原: HCN3
標(biāo) 記 物: Unconjugate
克隆類型: Unconjugate
Background:
This gene encodes a multi-pass membrane protein that functions as a voltage gated cation channel. The encoded protein is a member of a family of closely related cyclic adenosine monophosphate-binding channel proteins. Alternative splicing results in multiple transcript variants.
Applications:
ELISA, IHC
Name of antibody:
HCN3
Immunogen:
Synthetic peptide of human HCN3
Full name:
hyperpolarization activated cyclic nucleotide gated potassium channel 3
SwissProt:
Q9P1Z3
ELISA Recommended dilution:
5000-10000
IHC positive control:
Human colorectal cancer and human tonsil
IHC Recommend dilution:
25-100
技術(shù)規(guī)格

購物車
幫助
021-54845833/15800441009
